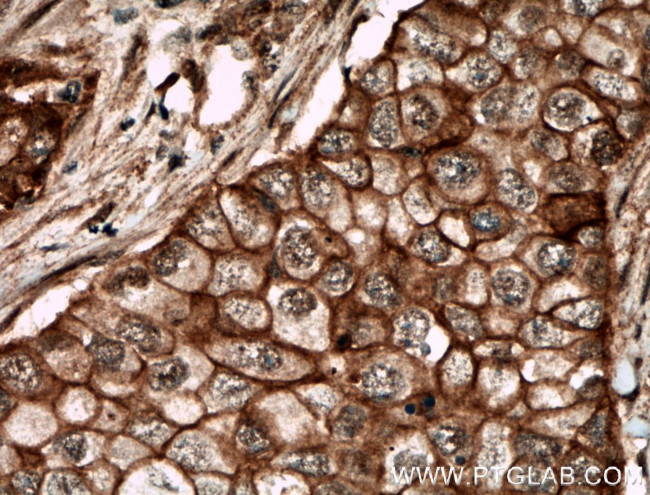
ECE1 Antibody in Immunohistochemistry (Paraffin) (IHC (P))

Search
Proteintech
ECE1 Polyclonal Antibody
{{$productOrderCtrl.translations['antibody.pdp.commerceCard.promotion.promotions']}}
{{$productOrderCtrl.translations['antibody.pdp.commerceCard.promotion.viewpromo']}}
{{$productOrderCtrl.translations['antibody.pdp.commerceCard.promotion.promocode']}}: {{promo.promoCode}} {{promo.promoTitle}} {{promo.promoDescription}}. {{$productOrderCtrl.translations['antibody.pdp.commerceCard.promotion.learnmore']}}
产品信息
26088-1-AP
种属反应
宿主/亚型
分类
类型
抗原
偶联物
形式
浓度
规格
纯化类型
保存液
内含物
保存条件
运输条件
产品详细信息
Immunogen sequence: TAAELQTLA PAINWLPFLN TIFYPVEINE SEPIVVYDKE YLEQISTLIN TTDRCLLNNY MIWNLVRKTS SFLDQRFQDA DEKFMEVMYG TK (335-425 aa encoded by BC126257)
靶标信息
Endothelin-converting enzyme 1 (ECE1) is located on chromosome 1p36.12 and encodes a zinc metalloprotease involved in the maturation of endothelin peptides, which are critical for vascular tone regulation and blood pressure control. ECE1 processes precursor proteins into active endothelins, particularly endothelin-1, the most potent vasoconstrictor known. This enzyme is expressed in multiple tissues, including endothelial cells, smooth muscle cells, and the central nervous system, where it participates in diverse physiological processes such as vasoconstriction, cell proliferation, and hormone secretion. Beyond its cardiovascular functions, ECE1 is implicated in neural development and neural crest cell migration. Dysregulation of ECE1 activity or endothelin signaling is associated with several pathologies, including hypertension, heart failure, and cancer progression due to its role in controlling vascular dynamics. Research into ECE1 aims to explore its therapeutic potential in managing cardiovascular disorders and its broader implications in systemic pathophysiology.
仅用于科研。不用于诊断过程。未经明确授权不得转售。
篇参考文献 (0)
生物信息学
蛋白别名: ECE 1; ECE-1; Endothelin-converting enzyme 1; unnamed protein product
基因别名: ECE; ECE1
UniProt ID: (Human) P42892
Entrez Gene ID: (Human) 1889